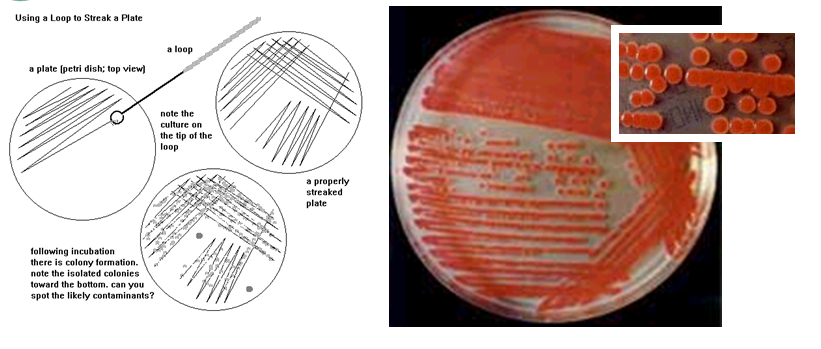
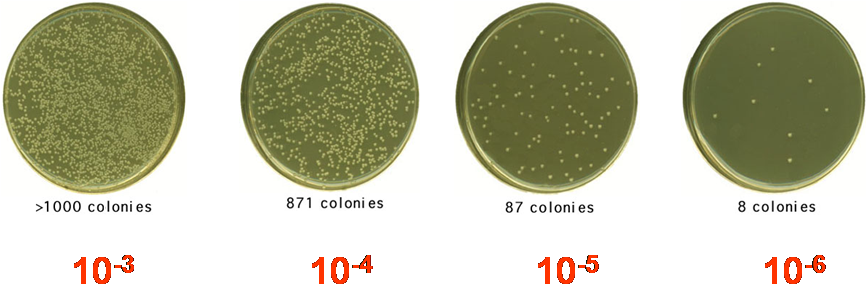

-
1 内容
-
2 练习
知识结构图

内容
微生物纯培养的分离
自然环境如土壤和水中,通常栖息着的是许多不同微生物混杂在一起的群体。哪怕是一粒砂或尘土,也常含有多种细菌及其它微生物。
研究微生物生长通常采用微生物纯培养。
微生物学中将在实验条件下从一个单细胞或一群相同的细胞繁殖得到的后代称为纯培养。

稀释平板分离法:
倾注平板法和涂布平板法。
基本过程:
◆ 梯度稀释过程
◆ 分离培养过程

平皿划线法:
用接种环沾少许待分离的材料,在培养基表面进行多次平行划线,使微生物细胞分开生长以获得微生物纯培养的过程。
单细胞挑取法:
从待分离材料中挑取一个细胞来培养,从而获得纯培养的过程。
微生物的培养方法
根据氧气的需要与否分为两大类:
好氧培养 厌氧培养
根据培养基的物理特性分为两大类:
固体培养 液体培养
微生物生长繁殖的测定方法

测生长量

比浊法:根据细菌悬浮液的吸光度测定其数量。优 点:简便,直接。

测繁殖数
◆ 直接法 总细胞计数法(血球计数板法)
◆ 间接法 活细胞计数法 平皿菌落计数法(CFU:菌落形成单位)

案例
比浊法测定微生物的生长
在微生物学研究和生产实践中,为及时了解液体培养过程中的微生物生长情况,需定时测定培养液中微生物的数量,以便适时地控制培养条件,获得最佳的培养物。
比浊法是根据菌悬液的细胞数与混浊度成正比,与透光度成反比的原理对微生物的生长进行测定的。
将样品放在一定体积的比色杯内,通过光电比色计或分光光度计测定样品中的OD值来代表培养液中的浊度,即生物量。此时测定的是微生物的总量,而无法区分死菌和活菌。适用于分散良好的非丝状单细胞微生物的测定。用此法测定液体发酵中的微生物生长情况,比用平板计数法能较快得出结果,可及时反馈,调控发酵条件,控制微生物的生长。
准备:大肠杆菌振荡培养8h和14h的培养物,分光光度计或光电比色计
方法:
1)将分光光度计的波长调整到450nm,开机预热10-15min。
2)在比色杯中盛未接种的培养液作为对照,进行零点调整。
3)将培养8h和14h的大肠杆菌菌液充分摇匀,分别倒入相同类型的比色杯中,测定其OD420值。若菌液浓度过大,可适当进行稀释,使OD420值的读数在0.0-0.4之间最好。每个样品重复测定2-3次。
4)测定后把比色杯中的菌液倾入容器中,用水冲洗比色杯,冲洗水也收集于容器中进行灭菌。最后用70%酒精洗比色杯,使比色杯自行晾干。
5)关闭分光光度计电源。

